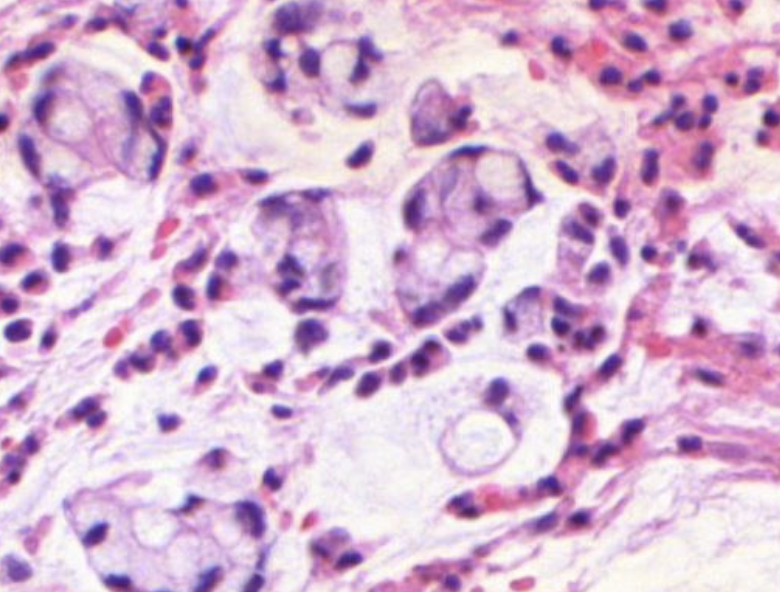
Histopathologisches Bild: Kolonschleimhaut

Übungsfragen: Tumorpathologie
Klicke auf „Antwort zeigen", um die Lösung anzuzeigen. Inhalte basieren auf der Vorlesung „Pathologie für Zahnmediziner:innen – Tumorpathologie". Tastaturnavigation: ↑↓ Pfeiltasten zum Navigieren, Enter zum Öffnen/Schließen, A für alle öffnen, S für alle schließen. Selbstbewertung: Alt/Option = Falsch, Cmd = Richtig.
Tumor = „Schwellung“ (kann entzündlich, degenerativ oder „echter“ Tumor sein). „Echter Tumor“ = Neoplasie/Neoplasma = Neubildung. Hamartom = Gewebsüberschuss- und Fehlbildung.
Zell- und Gewebsvermehrung, die nach Wegfall der auslösenden Ursache persistiert; klonale Entstehung aus einer Zelle; Vererbung der biologischen Eigenschaften auf Tochterzellen.
Tumorzellen (neoplastische Zellen), Tumorstroma (Bindegewebe/Gefäße), häufig begleitende Entzündungszellen.
Nach Ursprungszelle/Architektur. Benigne Epithel: Adenom (drüsig), Papillom (papillär). Maligne: Karzinom (epithelial), Sarkom (mesenchymal), Lymphom (lymphatisches Gewebe). Besonderheit: Teratom (mehrere Keimblätter: Ekto-/Ento-/Mesoderm).
Wiederholung der Agenda: Benignität vs. Malignität; Dysplasie; Tumorgenese (formal/molekular); Grading & Staging.
Für Patient:in/Behandler:in/Patholog:in: „gut oder böse?“ – basiert auf Morphologie, Tumorklassifikation, Lokalisation, Malignitätsgrad (Grading), Ausdehnung (Staging); diese determinieren Prognose und Therapie.
Benigne: glatt begrenzt, expansives Wachstum mit Kompression der Umgebung (z. B. uterines Leiomyom). Maligne: unscharf begrenzt, Infiltration/Invasion/Destruktion (z. B. invasives Mammakarzinom).
Benigne: gut differenziert (z. B. Plattenepithelpapillom). Maligne: Differenzierungsabschwächung/-verlust, Zellpolymorphie (z. B. wenig differenziertes Plattenepithelkarzinom).
Benignes Leiomyom: gleichförmige spindelige Zellen, gut differenziert. Leiomyosarkom: Polymorphie, Atypien, erhöhte Zellulärität, Hinweis auf Malignität.
Benigne: keine oder geringe Atypien, ggf. Polyploidie. Maligne: Kernvergrößerung, Polymorphie, Anisonukleose, Hyperchromasie, vermehrte/auffällige Nukleoli – illustriert am Vergleich Leiomyom vs. Leiomyosarkom.
Benigne: seltene Mitosen (ggf. etwas häufiger). Maligne: selten bis zahlreich, oft atypische Mitosen (z. B. tripolare Mitose) als Anaplasiezeichen.
Wachstum ergibt sich aus ΔProliferation – ΔApoptose pro Zeit; benigne meist langsam, maligne von langsam bis schnell (Beispielbild: Urothelkarzinom).
Benigne metastasieren nicht. Maligne metastasieren – gezeigt am Beispiel eines metastasierten Bronchialkarzinoms.
Tumoren mit lokaler Invasion, aber ohne Metastasierung; klassisches Beispiel: Basalzellkarzinom der Haut (invasiv destruktiv, aber nicht metastasierend).
Übergang zum Kapitel Dysplasie; danach Tumorgenese, Grading & Staging.
Allgemein: zelluläre/histologische Abweichung von der Norm. Epitheliale Dysplasie (intraepitheliale Neoplasie): gestörte Gewebedifferenzierung mit Verlust der Architektur, Zellformvariationen, Kernatypien und erhöhter Mitosezahl.
Graduierung: gering-/mäßiggradig („low“, Grad 1/2) vs. schwergradig („high“, Grad 3). Leicht/mäßig: potenziell reversibel. Schwer: Präkanzerose. Beispielbilder: cervikale Intraepitheliale Neoplasien (CIN).
Komplette Aufhebung der Epithelarchitektur mit starken Atypien in der gesamten Epithelhöhe, aber ohne Invasion der Basalmembran – daher „in situ“.
Abfolge: HPV-Infektion → virale Persistenz → Genexpressionsänderungen → genetische Instabilität → Virusintegration → Immortalisierung → Akkumulation genetischer Aberrationen (Onkogene/TSG) → Progress von unauffälligem Abstrich über niedrig-/hochgradige Läsion zum invasiven Karzinom (mit Metastasen); Unterscheidung Hoch- vs. Niedrigrisiko-HPV.
Histologisches Beispiel eines invasiv wachsenden Plattenepithelkarzinoms mit irregulären Tumorzellnestern in stromalem Gewebe.
Zervix: glanduläre Ektopie → Basalzellhyperplasie → Plattenepithelmetaplasie → HPV → Dysplasie 1–3 → CIS → invasives PE-Karzinom. Lunge/Bronchus (Rauchen): Basalzellhyperplasie → Metaplasie → Dysplasie 1–3 → CIS → invasiv. Mund/Rachen (Rauchen+Alkohol): Dysplasie 1–3 → CIS → invasives PE-Karzinom.
Adenom-Karzinom-Sequenz: Übergang von Hyperplasie/Frühadenom zu Schweradenom, Carcinoma in situ und Invasion/Metastase – histologisches Beispiel für glanduläre Dysplasien.
LGIEN: geringgradige Dysplasie mit moderaten architektonischen/karyologischen Abweichungen. HGIEN: hochgradige Dysplasie mit deutlicher Zell- und Architektur-Atypie – beide als Vorstufen in der Adenom-Karzinom-Sequenz.
Histologisches Beispiel eines invasiven Adenokarzinoms mit atypischen drüsigen Strukturen in desmoplastischem Stroma.
Typische Ereignisse: APC-Mutation (früh), aberrante Krypten → frühes Adenom; KRAS-Mutation, DNA-Methylierung, 18q-LOH; später p53-Mutation/LOH → Progression über CIS zu Invasion/Metastase. Umweltfaktoren modulieren diese Intrinsik.
Einstieg in D) formale/molekulare Tumorgenese und E) Grading/Staging.
Tumorgrad („grading“), Tumorstadium („staging“) und Tumorprognosefaktoren.
Grundidee: Je undifferenzierter, desto schnelleres Wachstum, höhere Strahlenempfindlichkeit und Bösartigkeit. Erst: gutartig vs. bösartig; dann Differenzierungs-/Malignitätsgrad: G1 (hoch differenziert), G2 (mittel), G3 (gering differenziert).
Beispiel einer Karzinomhistologie (Drüsenstrukturen in fibrotischem Stroma) zur Veranschaulichung von Differenzierungsmerkmalen, die in die Gradbeurteilung einfließen.
Nach histologischer Typisierung/Differenzierung, Kernatypie und Mitosen. Beispiele: Tubulusbildung (>75%, 10–75%, <10%), Kernpolymorphie (gering/mittel/stark) und Mitoserate (pro HPF) werden als Score summiert → Summe 3–9 → Malignitätsgrad G1–G3.
Visuelle Orientierung zur Identifikation von Tubulusbildung, Kernatypie und Mitosen in realen Schnittpräparaten als Grundlage der Scorevergabe.
Kernatypien und Mitosen in höherer Vergrößerung zur sicheren Erkennung der Kriterien (z. B. pleomorphe Kerne, auffällige Mitosen) für die Gradbestimmung.
Entitäten-spezifisch: Kolorektales Epithel – klar benigne vs. maligne; Ovarialepithel – Spektrum benigne/borderline/malign; Weichgewebe – Kategorien benign/intermediate (lokal aggressiv oder selten metastasierend)/malign → zeigt die Notwendigkeit entitätsspezifischer Klassifikation.
Zytologische Atypien bei fehlender größerer Invasion; Möglichkeit der „Mikroinvasion“ <5 mm und cavitärer Implants – klinisch zwischen benigne und maligne, relevant für Management/Prognose.
T: Primärtumor-Ausdehnung (T0–T4); N: regionäre Lymphknoten (N0–N3); M: Fernmetastasen (M0/M1). Präfixe: c (klinisch), p (pathologisch). Dient Prognose, Therapieplanung und Studienvergleich.
pT: Ausdehnung inkl. pTis (in situ); Zusatz L1/V1 für Lymph-/Blutgefäßeinbruch; R-Status (R0: kein Residualtumor; R1: mikroskopisch; R2: makroskopisch). pN: Lymphknotenstatus (pNx, pN0, pN1–3, pN4). pM: Fernmetastasen (pMx, pM0, pM1).
Definition der Tumorprogression (kontinuierliche Zunahme von Malignität) und Erklärung des metastatischen Prozesses: lokale Invasion → intravasale Dissemination → Zelladhäsion → Extravasation → Kolonisation → Wachstum im Zielorgan.
(1) Invasion (lokale Durchbrechung der Basalmembran), (2) Intravasation (Eintritt in Blut-/Lymphgefäße), (3) Transport im Kreislauf, (4) Extravasation (Austritt im Zielgewebe), (5) Kolonisation (Anwachsen im neuen Milieu), (6) Angiogenese (Gefäßneubildung zur Versorgung der Metastase).
Matrix-Metalloproteinasen (MMP-2, MMP-9), Urokinase, Cathepsine – degradieren Basalmembran/ECM. Tumorzellen: Integrine/Adhäsionsmoleküle (CD44, E-Cadherin↓) → erhöhte Motilität/Migration.
1️⃣ lymphogen (v. a. Karzinome), 2️⃣ hämatogen (v. a. Sarkome; z. B. Leber/Lunge), 3️⃣ kavitäre Aussaat (Serosa-/Liquorräume), 4️⃣ iatrogene Implantation (OP-Verschleppung).
Beispiele: Mamma → axillär → supraklavikulär; Zunge → submandibulär → zervikal; Magen → Virchow-LK (linke Supraklavikularregion). Lymphknotenstatus zentral für pN und Prognose.
Primärtumor → Einbruch in Venen → Lunge (Körpervenen) oder Leber (Pfortader) → weitere Organmetastasen (z. B. Gehirn, Knochen). Beispiele: Kolonkarzinom → Leber; Bronchialkarzinom → Gehirn/Nebenniere.
Tumorzellen sezernieren VEGF, bFGF → Gefäßneubildung, Versorgung des Tumors mit O₂/Nährstoffen; erleichtert Metastasierung. Angiogenesehemmung (z. B. Bevacizumab) als Therapieprinzip.
Metastasierung hängt von Eigenschaften der Tumorzelle („seed“) und vom Milieu des Zielorgans („soil“) ab → organspezifische Metastasierung (z. B. Prostata → Knochen, Kolon → Leber).
Onkogene, Tumorsuppressorgene, Apoptosegene, DNA-Reparaturgene, Telomerase, Mikroumgebungs-/Immuninteraktionsgene.
Proto-Onkogene → Mutation, Amplifikation, Translokation oder virale Aktivierung → Onkogene mit konstitutiven Proliferationssignalen. Beispiel: RAS-Mutation → dauerhafte MAP-Kinasen-Aktivierung.
TP53 („guardian of the genome“) – DNA-Schadensantwort/Apoptose; RB1 – G1/S-Checkpoint; APC – WNT-Signalhemmung (Kolonkarzinom); BRCA1/2 – Reparatur doppelsträngiger DNA-Brüche.
Aktivierung von Onkogenen, Inaktivierung von Tumorsuppressorgenen, Apoptosehemmung (BCL-2↑, p53↓), Telomeraseaktivierung, epigenetisches Silencing (Promotormethylierung).
Mutation mit funktionellem Selektionsvorteil, die Tumorentstehung/-progression aktiv vorantreibt (vs. „passenger mutations“ ohne selektiven Vorteil).
Defekte DNA-Reparatur steigern Mutationsrate → Akkumulation genetischer Veränderungen → Tumorprogression (Beispiel: HNPCC, Mismatch-Repair-Defekte, Microsatellite Instability).
Telomerverkürzung, fehlerhafte DNA-Replikation, chromosomale Translokationen, Aneuploidie, Defekte in Spindelkontrolle, defekte Checkpoints (p53, ATM/ATR).
Tumorzellen vermeiden Apoptose durch BCL-2-Überexpression, p53-Inaktivierung, Caspase-Inhibition → Überleben trotz DNA-Schaden, Förderung von Chemo-/Strahlenresistenz.
Kernfähigkeiten: (1) autonome Proliferation, (2) Resistenz gegen Wachstumshemmung, (3) Vermeidung von Apoptose, (4) immortales Wachstum (Telomerase), (5) Angiogenese, (6) Invasion/Metastasierung; ergänzt um (7) Stoffwechselreprogrammierung, (8) Immunflucht.
RAS/MAPK-, PI3K/AKT-, WNT/β-Catenin-, p53-, TGF-β-, Notch-, Hedgehog-, JAK/STAT-, Hippo-Pathways – steuern Zellzyklus, Differenzierung, Überleben.
Verlust von Polarität/Zell-Zell-Adhäsion (E-Cadherin↓), Erwerb mesenchymaler Eigenschaften (Vimentin↑) → erhöhte Motilität, Invasivität, Resistenz; zentral für Metastasierung.
Immunüberwachung (Eliminierung), Immunselektion (Escape-Varianten überleben), Immunescape (PD-L1, Tregs). Immuntherapie reaktiviert T-Zell-Antwort (Checkpoint-Inhibitoren).
Proteine, die von Tumorzellen überexprimiert/mutiert exprimiert werden (z. B. CEA, AFP, Her2/neu, MUC1, p53-Mutant); diagnostisch (Marker) und therapeutisch nutzbar (Antikörper, Impfstoffe).
Modell aus drei Phasen: Elimination → Equilibrium → Escape. Immunsystem selektiert Zellen mit reduzierter Immunogenität; Escape-Varianten dominieren.
MHC-I-Downregulation, PD-L1-Überexpression, Sekretion immunsuppressiver Zytokine (TGF-β, IL-10), Rekrutierung von Tregs/MDSCs → verminderte CTL-Erkennung.
Stroma, Fibroblasten, Makrophagen, Gefäße und ECM bilden ein dynamisches Milieu, das Wachstum, Angiogenese und Immunflucht moduliert; CAF fördern EMT/Metastasierung.
Intratumorale genetische/phänotypische Diversität → Teilklone mit variabler Therapieempfindlichkeit; intertumoral = Unterschiede zwischen Patient:innen/Entitäten; Herausforderung für Präzisionsmedizin.
Immunhistochemie, FISH, PCR, NGS – Nachweis spezifischer Mutationen (EGFR, KRAS, ALK), Expressionsmuster (ER/PR/Her2) → Grundlage personalisierter Therapie.
HER2 (Trastuzumab), EGFR (TKIs), BRAF (Vemurafenib), ALK (Crizotinib), PD-L1 (Checkpoint-Therapie), MSI (Immuntherapie-Ansprechen); Companion Diagnostics essenziell.
Antikörper blockieren inhibitorische Signale (PD-1/PD-L1, CTLA-4), reaktivieren zytotoxische T-Zellen und ermöglichen Tumorzellzerstörung; besonders wirksam bei immunogenen Tumoren (Melanom, Lunge, HNSCC).
Keimbahnmutationen: BRCA1/2 (Mamma/Ovar), APC (FAP), TP53 (Li-Fraumeni), VHL (Von-Hippel-Lindau), RET (MEN) → genetisches Screening/Surveillance empfohlen.
Mehrstufiger Prozess mit sukzessiver Akkumulation genetischer/epigenetischer Veränderungen; jede Mutation verleiht klonalen Vorteil (darwinistische Selektion).
Anaplasie, Pleomorphie, Mitosen, Invasion, Metastasen, Desmoplasie, Nekrosen – bleiben trotz molekularer Fortschritte Grundlage der histopathologischen Diagnose.
Tumorpathologie verbindet Morphologie und Molekularpathologie. Verständnis von Grading, Staging und molekularen Veränderungen ist Basis präziser Diagnostik, Prognose und zielgerichteter Therapie – „Keine Therapie ohne Diagnose – keine Diagnose ohne Pathologie.“

Hier zu sehen ist eine Colon Mukosa (Schleimhaut).
Zu erkennen daran, dass es nur Krypten und keine Zotten gibt.

Hier zu sehen ist eine Lipom im Kolon.
Es ist als gutartig anzusehen, weil die Fettzellen stark differenziert sind und keine Zellveränderungen zu sehen sind.
Man erkennt erst das es ein Tumor ist, weil es sich Gewebsdrägend verhält, die darüberliegende Colonschleimhaut wird schmal erdrückt.

Hier zu sehen ist eine Lebergewebe.
Erkennbar an den Sinusioiden und der Struktur der aneinander haftenden Zellen. Mittig erkennt man eine Zentralvene

Hier zu sehen sind Gallengänge im Lebergewebe.

Kavernöses Hämangiom.
Es zeigen sich unterchiedlich weite Blutgefäße und darin ganz viele Erythrozyten.
Wenn diese Gefäße super groß werden, dann nennt man die Kavernös. Vaskuläre tumoren sind in der Leber recht häufig

Thrombosieren der Kavernen und Nekrosen darin.

Es zeigt sich die Mukosa des Colons. Daran zu erkennen das keine Zotten aber Krypten zu sehen sind. Kennzeichen einer guten Krypte: Bis oben hin becherzellartig.

Es zeigt sich das coronal an de Krypten die Becherzellen fehlen am Grund jedoch noch einige Becherzellen in den Untenständigenzellen vorhanden sind

Tubuläres Adenom der colon schleimhaut. Kerne vergrößert, keine Becherzellen darin vorhanden. Zellbild sieht anders aus.

Bei Karzinomen der Darmschleimhaut (z. B. im Kolon oder Rektum) ist die anatomische Grenze, ab der man von einem invasiven Karzinom spricht, das Überschreiten der Muscularis mucosae..

Es zeigt sich Lymphatisches Gewebe der Colonschleimhaut, sogenannte Pleyer Plaques.


Colonkarzinom. Links sieht es recht unordentlich aus. Es zeigen sich in kleinen pools auch leukozyten und Fibrin. Hier sind auch super viele Zellen zu sehen .
Siegelringzellen. Diese Siegelringzellen laufen gerne einzeln durch den Tumor. Siegelringzellen sind schlecht für die Prognose. .